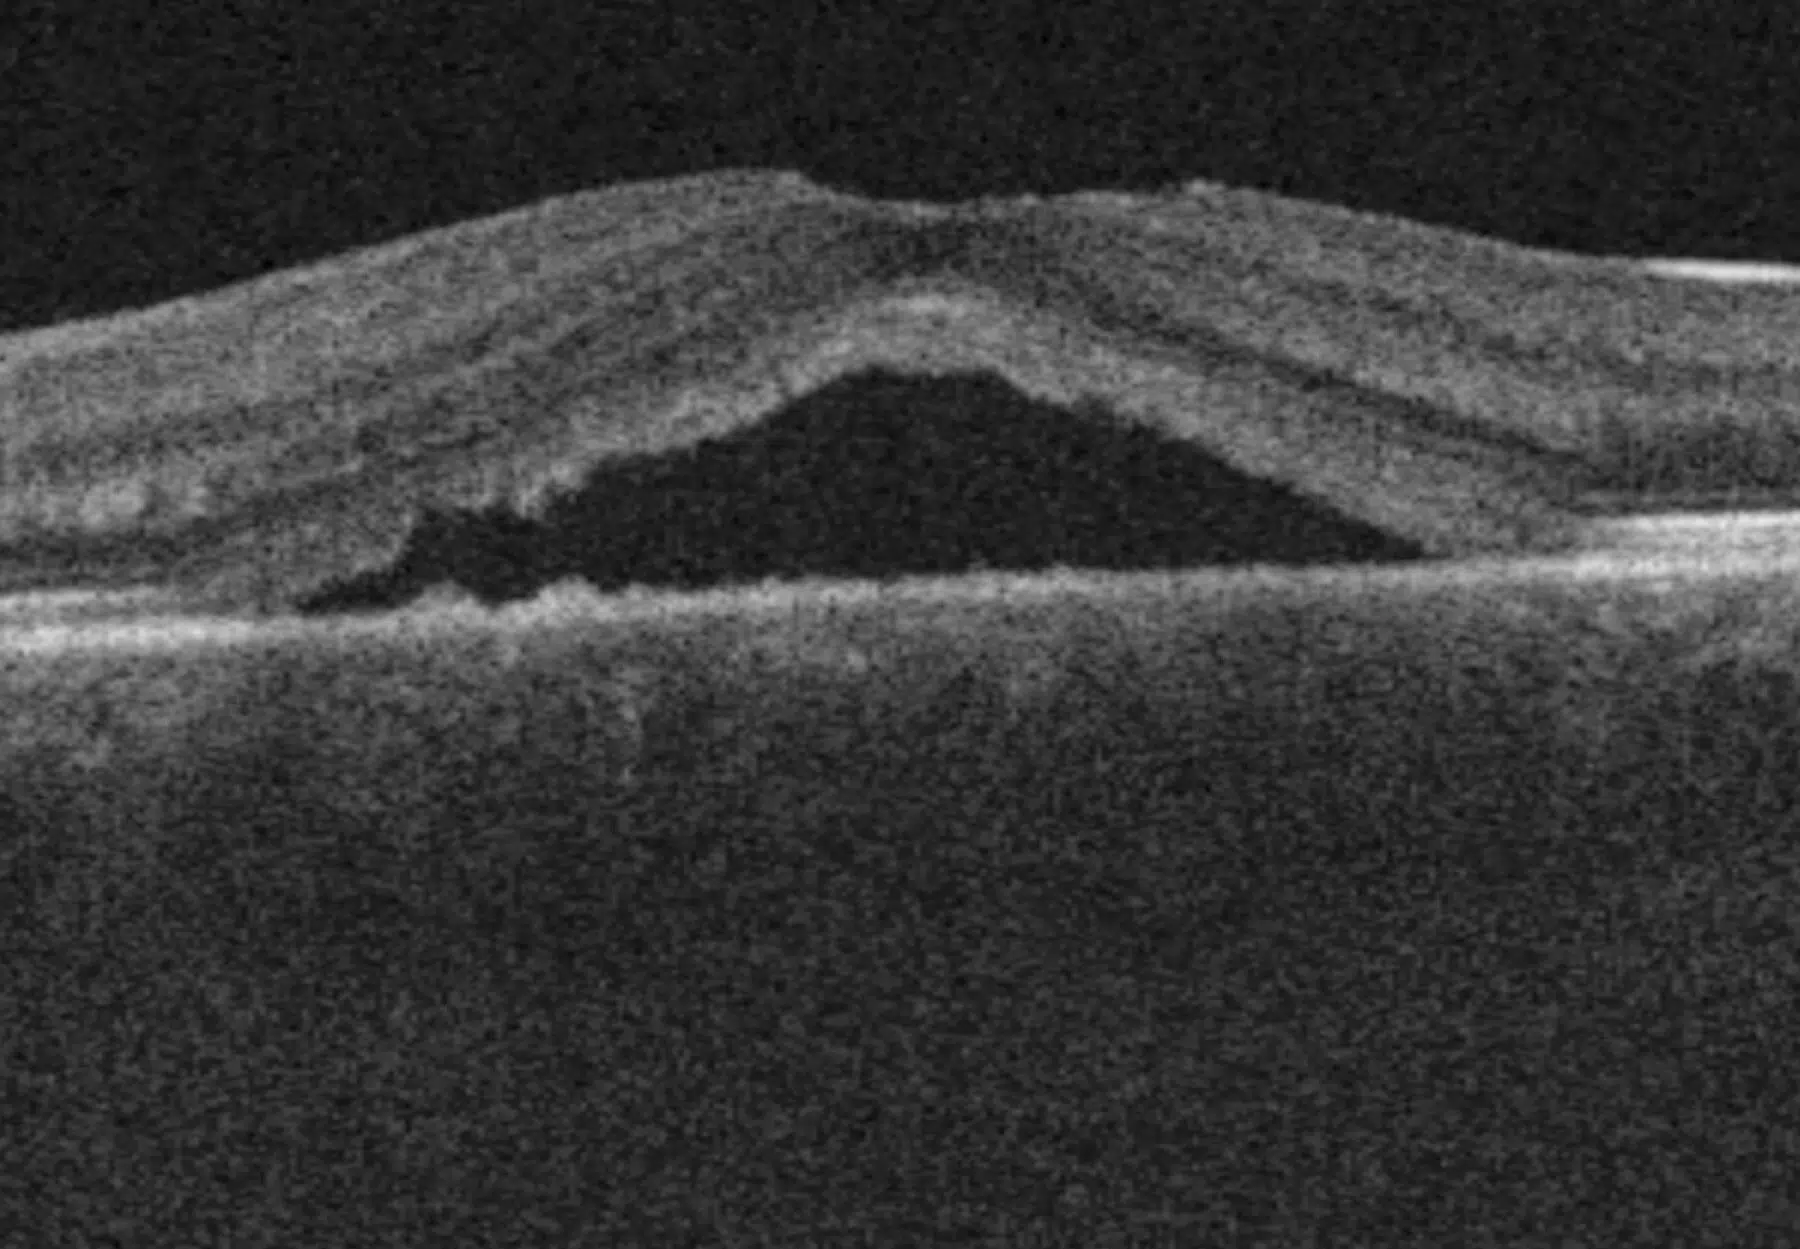

La choriorétinopathie séreuse centrale est causée par une fuite de liquide sous la rétine, à proximité de l’épithélium pigmentaire, provoquant un décollement localisé. Elle affecte le plus souvent la macula, zone responsable de la vision fine. Ses symptômes incluent une baisse de vision, des métamorphopsies (lignes ondulées), ou encore des zones sombres dans le champ de vision.
Choriorétinopathie séreuse centrale
La choriorétinopathie séreuse centrale (CRSC) est une pathologie de la macula caractérisée par une accumulation de liquide sous-rétinien. Elle touche surtout les jeunes hommes actifs et peut provoquer une altération de la vision centrale, parfois durable en cas de récidives. Une surveillance ophtalmologique est souvent suffisante, mais des traitements ciblés existent pour les formes chroniques.
La choriorétinopathie séreuse centrale en quelques mots
Qui est concerné par la CRSC ?
Bien que plus fréquente chez les hommes de 20 à 50 ans, la CRSC peut aussi survenir chez les femmes enceintes. Plusieurs facteurs de risque ont été identifiés :
- Corticothérapie récente (toutes voies confondues) ;
- Hypercortisolémie ;
- Stress psychologique ;
- Antécédents familiaux de la maladie.
Les symptômes de la Choriorétinopathie Séreuse Centrale
Les signes les plus fréquents sont :
- Baisse d’acuité visuelle avec scotome central ;
- Perception faussée des objets (grandeur ou forme) ;
- Modification des couleurs ;
- Réduction des contrastes, surtout en faible luminosité.
Comment diagnostiquer la CRSC ?
Le diagnostic repose sur plusieurs outils :
- Examen du fond d’œil : permet la détection des zones de décollement ;
- OCT : un outil clé pour observer la structure rétinienne et évaluer la résolution ;
- Angiographie à la fluorescéine : pour localiser les fuites vasculaires actives ;
- Autofluorescence : utile pour les formes récidivantes.
Les traitements de la Choriorétinopathie Séreuse Centrale
La surveillance régulière est souvent suffisante. En cas de persistance, et selon le type de CRSC, une photocoagulation au laser ou une photothérapie dynamique (PDT) est recommandée.
Dans certains cas, un traitement par éplérénone (hors AMM) peut être nécessaire.
Évolution et pronostic
La CRSC disparaît en général en quelques mois, mais peut devenir chronique ou récidivante. Des séquelles fonctionnelles sont possibles, surtout en cas d’atteinte bilatérale ou de dégénérescence maculaire associée.
Le Pôle Ophtalmologique Issy-les-Moulineaux assure un suivi de précision grâce à ses technologies de pointe, pour préserver la qualité visuelle à long terme.
